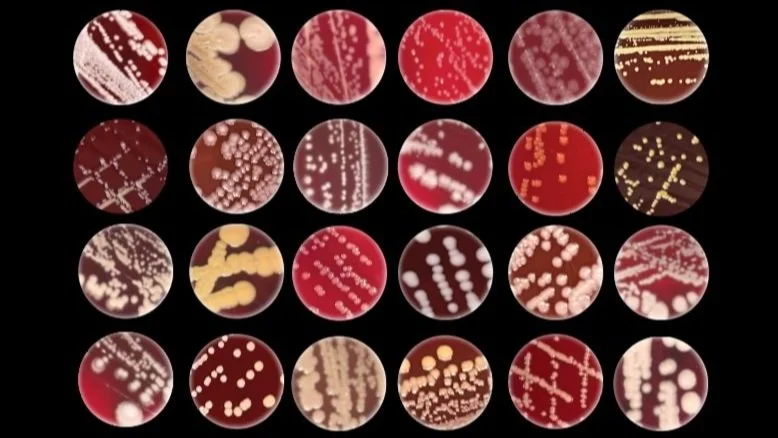

Artwork by ©Lisa Ohman, Ph.D.
Lab Culture and Values
-

Learning together
We are a team of scientists exploring the fascinating world of microbes and their interactions with skin, delving deeper into our understanding of ourselves.
-

Lab Values
We aim to foster a supportive environment. We prioritize work-life balance, celebrate achievements, community, and support growth mindset.
-
Community and belonging
Microbial diversity boosts health, growth, and upholds balance in the ecosystem. Our lab values community as vital for innovative research, blending unique perspectives to drive groundbreaking discoveries.
-

Mentoring
We collaborate to advance scientific knowledge, ensuring your skill development aligns with career goals through a strategic and adaptable plan tailored to your journey in academia and research.
-

Meeting and activities
We conduct weekly meetings in various formats including roundtable discussions, brainstorming sessions, and problem-solving. One lab member selects a microbe of the month featured on our lab floor! We have a lab blog where individual members contribute.
-

Lab Space
Our lab is located in the heart of the Washington University School of Medicine campus steps away from McDonnell Pediatric Research Building, BJC and key science facilities. Our floor is also home to other colleagues from the Laboratory & Genomic Medicine Division.

